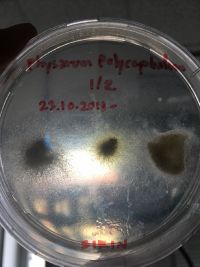

GMU:DIY Bio: doing things with biology/Sirin Unmanee/23.10.2018 : Growing Physarum polycephalum (1st attempt): Difference between revisions
(Created page with "Physarum polycephalum, often referred to as the “many-headed slime,” is a slime mold that inhabits shady, cool, moist areas, such as decaying leaves and logs. It is typica...") |
No edit summary |
||
| (5 intermediate revisions by the same user not shown) | |||
| Line 7: | Line 7: | ||
[[File:S__3096603.jpg|200px]] [[File:S__3096602.jpg|200px]] | [[File:S__3096603.jpg|200px]] [[File:S__3096602.jpg|200px]] | ||
<br/>''23.10.2018 - 20:30'' | |||
'' | [[File:S__3104951.jpg|200px]] [[File:S__3104952.jpg|200px]] | ||
<br/>''25.10.2018 - 19:30'' | |||
[[File: | [[File:S__3178584.jpg|200px]] [[File:S__3178585.jpg|200px]] | ||
<br/>''30.10.2018 - 19:30'' | |||
After one week, I don't really notice any differences. The Slime Mold in the first dish (1/2) is slightly growing, but in another dish (2/2) might be already died. However, I will keep documenting both of them. | |||
'' | [[File:S__3186893.jpg|200px]] | ||
<br/>''01.11.2018 - 10:30'' | |||
I decided to keep just the first dish (1/2), since slime mold in another dish is already died. Two days after I moved the dish to be placed in the lab, there is some few differences. | |||
---------------------------------- | |||
After | After three weeks, slime mold in both dishes died due to the unsuitable temperature. To sum up, one of the most important factors for growing slime mold is the environment. For me now, I can grow them only in the lab. | ||
Latest revision as of 10:00, 7 November 2018
Physarum polycephalum, often referred to as the “many-headed slime,” is a slime mold that inhabits shady, cool, moist areas, such as decaying leaves and logs. It is typically yellow in color, and eats fungal spores, bacteria, and other microbes. It shuns light, but light also triggers spore production. (source : [1])
The medium for the slime mold includes 2% agar and 98% still-water. For my experiment, I added two types of food for each slime mold, oat and cornflake, to see which one that it prefers.
I experiment with two dishes. I place the first dish (1/2) inside my wardrobe and place another dish (2/2) on my heater.
After one week, I don't really notice any differences. The Slime Mold in the first dish (1/2) is slightly growing, but in another dish (2/2) might be already died. However, I will keep documenting both of them.
I decided to keep just the first dish (1/2), since slime mold in another dish is already died. Two days after I moved the dish to be placed in the lab, there is some few differences.
After three weeks, slime mold in both dishes died due to the unsuitable temperature. To sum up, one of the most important factors for growing slime mold is the environment. For me now, I can grow them only in the lab.